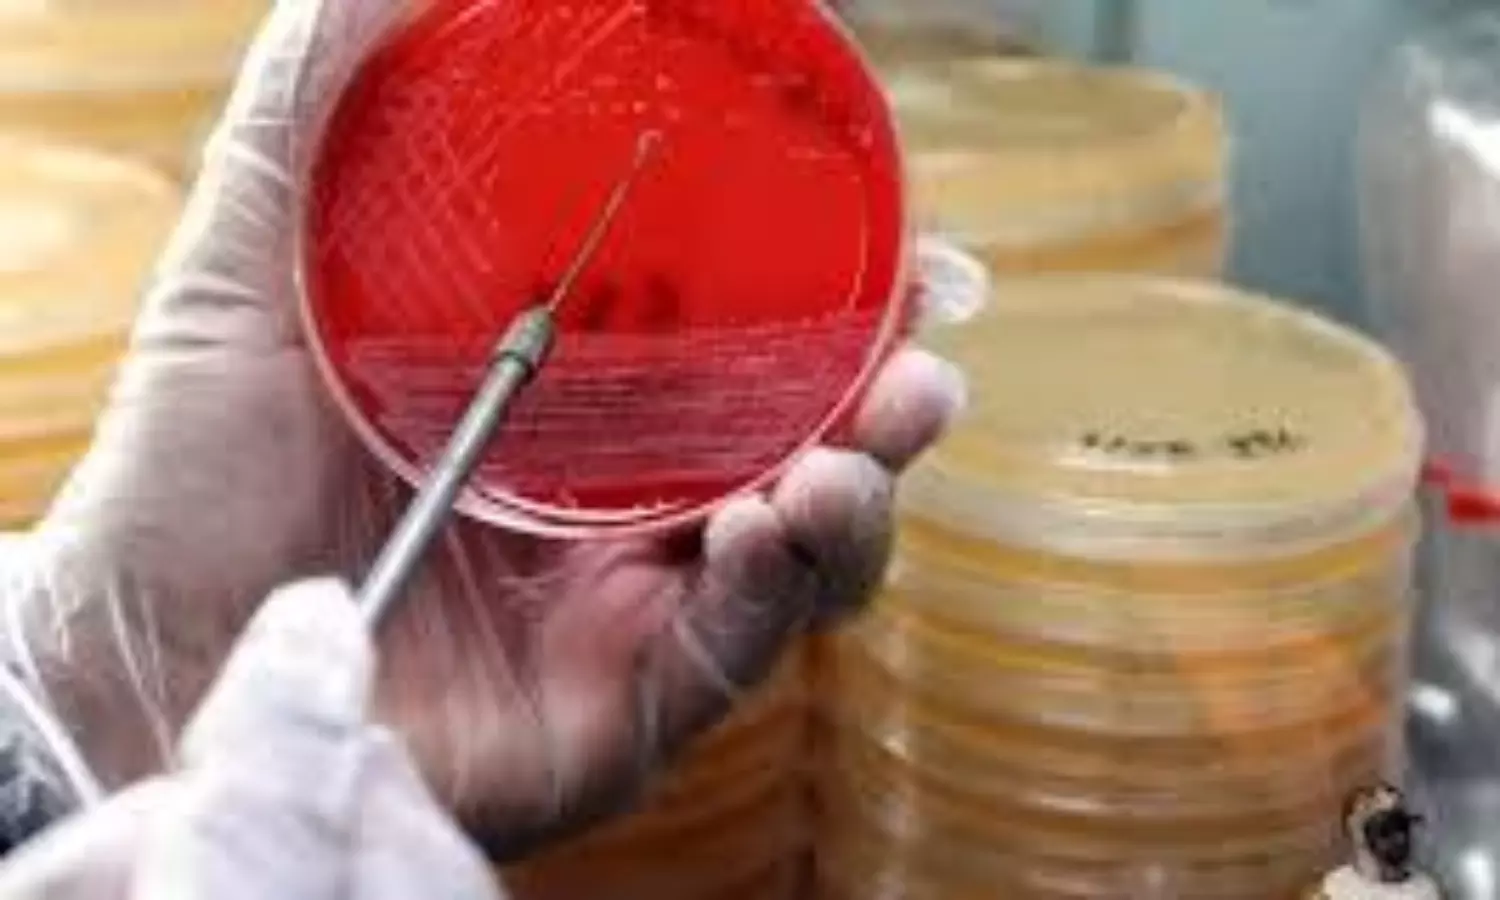
typhoid

ARCHIVE SiteMap 2025-07-15
 Bangladesh government to demolish Satyajit Ray’s ancestral home, Mamata Banerjee seeks Centre's intervention
Bangladesh government to demolish Satyajit Ray’s ancestral home, Mamata Banerjee seeks Centre's intervention Drug-resistant typhoid on the rise, spreading globally at alarming rate: study
Drug-resistant typhoid on the rise, spreading globally at alarming rate: study Maha govt issues order for action against unauthorised slaughterhouses
Maha govt issues order for action against unauthorised slaughterhouses Sexual assault on train: Man sentenced to life for assaulting pregnant woman
Sexual assault on train: Man sentenced to life for assaulting pregnant woman Madras HC orders suspension of cop for inaction in jewellery theft case, slams lapses in investigations
Madras HC orders suspension of cop for inaction in jewellery theft case, slams lapses in investigations Tamil Nadu rolls out ‘Ungaludan Stalin’ scheme for doorstep delivery of public services
Tamil Nadu rolls out ‘Ungaludan Stalin’ scheme for doorstep delivery of public services Bail granted to Rahul Gandhi by Lucknow court in defamation case
Bail granted to Rahul Gandhi by Lucknow court in defamation case India’s unemployment rate remains at 5.6% amid urban-rural divergence
India’s unemployment rate remains at 5.6% amid urban-rural divergence Over 300 fake ‘babas’ caught in Uttarakhand under Operation Kalnemi
Over 300 fake ‘babas’ caught in Uttarakhand under Operation Kalnemi S Jaishankar delivers firm call against terrorism during first China visit since Galwan clash
S Jaishankar delivers firm call against terrorism during first China visit since Galwan clash Kuwait, France strengthen ties during Amir’s official visit to Paris
Kuwait, France strengthen ties during Amir’s official visit to Paris Arijit Singh set for directorial debut with film produced by Mahaveer Jain
Arijit Singh set for directorial debut with film produced by Mahaveer Jain